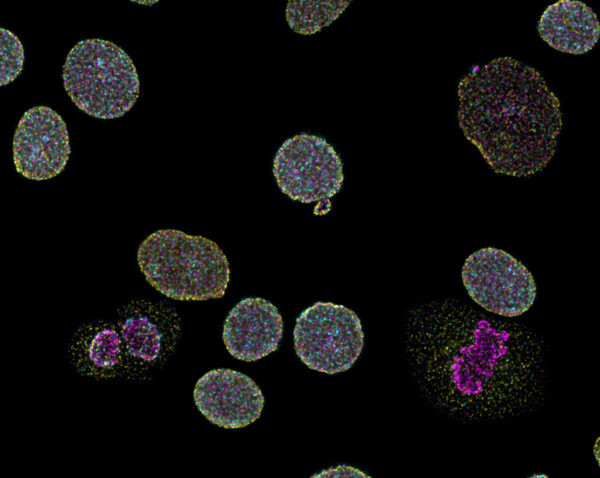
Naveni Triflex Cell MR

Cookie preferences
This website uses cookies, which are necessary for the technical operation of the website and are always set. Other cookies, which increase the comfort when using this website, are used for direct advertising or to facilitate interaction with other websites and social networks, are only set with your consent.
Configuration
Technically required
These cookies are necessary for the basic functions of the shop.
"Allow all cookies" cookie
"Decline all cookies" cookie
CSRF token
Cookie preferences
Currency change
Customer-specific caching
FACT-Finder tracking
Individual prices
Selected shop
Session
Comfort functions
These cookies are used to make the shopping experience even more appealing, for example for the recognition of the visitor.
Note
Show the facebook fanpage in the right blod sidebar
Statistics & Tracking
Affiliate program
Conversion and usertracking via Google Tag Manager
Track device being used
| Item number | Size | Datasheet | Manual | SDS | Delivery time | Quantity | Price |
|---|---|---|---|---|---|---|---|
| NAV-TF.100.MR.100 | 1 kit (4 mL, 100 rxns) | - |
7 - 10 business days* |
2,928.00€
|
If you have any questions, please use our Contact Form.
You can also order by e-mail: info@biomol.com
Larger quantity required? Request bulk
You can also order by e-mail: info@biomol.com
Larger quantity required? Request bulk
Detect and quantify total protein A, total protein B, and the interaction AB between the two... more
Product information "Naveni Triflex Cell MR"
Detect and quantify total protein A, total protein B, and the interaction AB between the two proteins. The assay is designed to be used with a mouse and rabbit primary antibody pair. The NaveniTMTriFlex Cell MR is an in situ kit, to be used with the user's primary antibodies of choice (raised in mouse and rabbit). The kit enables fluorescent staining of protein-protein interactions, concurrently visualizing the two proteins in their free state. Compatible with traditional immunostaining equipment, the kit uses Navenibody detection to produce the amplified signals facilitating immediate quantification of the readout, three fluorophores are included requiring the filters FITC, Cy3 and Cy5. The kit is based on our?NaveniTM?Proximity Ligation Technology,?with TriFlex Navenibodies?conjugated to proprietary oligo arms. The technology ensures specific and sensitive detection (learn more about NaveniTMTriFlex here). The kit has been validated on cell samples. Included in the kit:? Anti-mouse Navenibody? Anti-rabbit Navenibody Three detection fluorophores requiring filter sets for FITC (rabbit antibody signal), Cy3 (mouse antibody signal), Cy5 (proximity signal). Buffers for blocking and dilutions, and all detection reagents The Navenibody solution has a working volume of 4000µl (sufficient for approx. 100 reactions)
| Supplier: | Navinci |
| Supplier-Nr: | TF.100.MR |
Properties
| Application: | PLA, protein-protein interaction studies |
Database Information
Handling & Safety
| Storage: | vT |
| Shipping: | +4°C (International: +4°C) |
Caution
Our products are for laboratory research use only: Not for administration to humans!
Our products are for laboratory research use only: Not for administration to humans!
Information about the product reference will follow.
more
You will get a certificate here
Viewed

